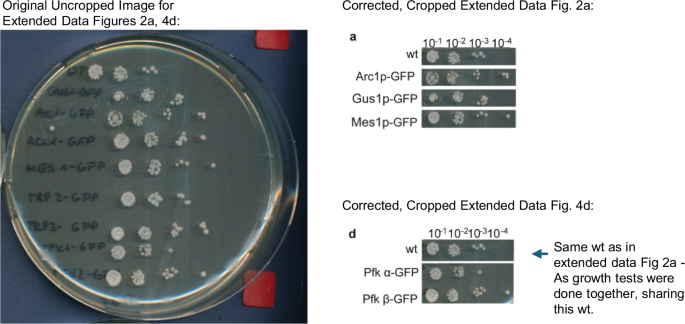
Author Correction: Cotranslational assembly of protein complexes in eukaryotes revealed by ribosome profiling

"In the originally published version of this article, Extended Data Fig. 4d was inadvertently presented as a partial duplicate of Extended Data Fig. 2a, and the strains in both panels were partially misannotated. This occurred due to an error during figure preparation, as the assays for multiple strains were performed together on the same petri dish, sharing a wild-type control and yielding highly similar phenotypes."
"The corrected Extended Data Fig. 2a & 4d are now available as Fig. 1, below. These corrections do not affect the results or conclusions of the study. Fig. 1 Corrected Extended Data Fig. 2a & 4d."
Extended Data Fig. 4d was inadvertently presented as a partial duplicate of Extended Data Fig. 2a, and strains in both panels were partially misannotated. The error arose during figure preparation because assays for multiple strains were performed together on the same petri dish, sharing a wild-type control and yielding highly similar phenotypes. Corrected Extended Data Fig. 2a and 4d are provided as Fig. 1. The corrections do not affect the experimental results or study conclusions.
Read at www.nature.com
Unable to calculate read time
Collection
[
|
...
]